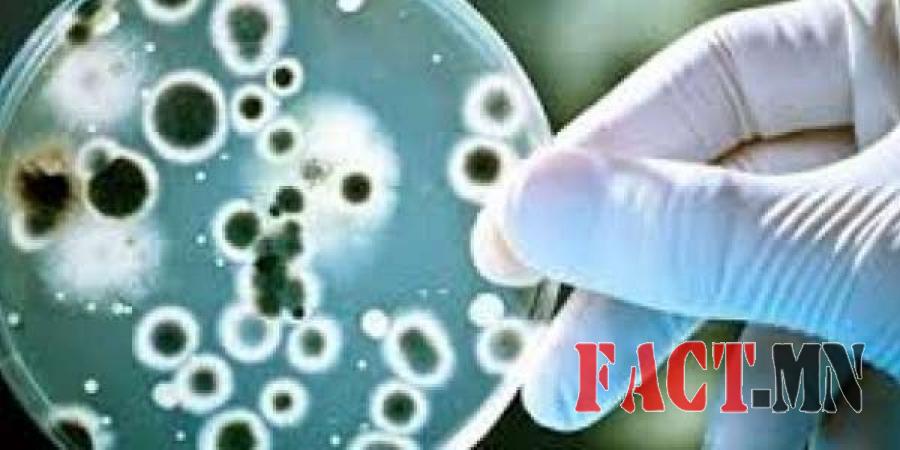

Бруцеллёз өвчний оношлогоог олон улсын түвшинд хийнэ
Улсын Мал эмнэлгийн ариун цэврийн төв лабораторт малын бруцеллёзын лавлагаа лаборатортой боллоо. Энэхүү лабораторийн талаар зарим зүйлийг Швейцарийн хөгжлийн агентлагийн Малын эрүүл мэндийн төслийн ажилтан Б. Золзаяатайгаас тодрууллаа.
-Малын бруцеллёзын лавлагаа лаборатортой боллоо. Уг лавлагаа лаборатори байгуулагдсанаар ямар давуу талууд бий болж байгаа вэ?
-Малын бруцеллёзын лавлагаа лаборатортой боллоо. Уг лавлагаа лаборатори байгуулагдсанаар ямар давуу талууд бий болж байгаа вэ?
-Улсын Мал эмнэлгийн ариун цэврийн төв лабораторт малын бруцеллёзын лавлагаа лаборатори байгуулагдсанаар манай улс бруцеллёзийн оношлогоог олон улсын төвшинд хийх боломжтой болно. 2012 оноос Швейцарийн хөгжлийн агентлагийн “Малын эрүүл мэнд” төсөл нь Улсын Мал эмнэлгийн ариун цэврийн төв лаборатортой хамтран ажиллаж “Бруцеллёзын лавлагаа лаборатори” байгуулах ажилд нь дэмжлэг үзүүлсэн. Уг ажлын хүрээнд бруцеллёзын үндэсний лавлагаа ийлдсийн сан байгуулах, олон улсын мэргэжилтнүүдийг урьж ажиллуулах болон шаардлагатай багаж, тоног төхөөрөмж, урвалж худалдан авах гэх мэт ажлууд хийгдсэн. Нийт 200 гаруй сая төгрөгийн санхүүжилтийг төслийн зүгээс хийсэн байгаа.
-Өмнө нь бруцеллёз өвчний шинжилгээг яаж хийдэг байсан юм бэ?
-Бруцеллёз өвчин цочмог болон далд хэлбэрээр илэрдэг нянгийн гаралтай мал, амьтнаас хүнд халдварладаг өвчин. Малын эд эс, цус, зулбасан ураг болон голдуу гэмтсэн ихэстэй хүрэлцэх, халдвартай малын сүү, цагаан идээ хэрэглэх үед хүнд халдварладаг өвчнүүдийн нэг юм. Уг өвчин нь хүн амын эрүүл мэнд, мал сүргийн үржил ашиг шимд сөргөөр нөлөөлж, нийгэм, эдийн засагт ихээхэн хохирол учруулдаг. Тиймээс бруцеллёзын халдвар авсан малыг цаг алдалгүй, үнэн зөв оношлох нь нийтийн эрүүл мэндийг хамгаалах, малын бруцеллёзыг хяналтандаа авахад ихээхэн ач холбогдолтой юм. Өмнө нь бол бруцеллёз өвчин байна гэдгийг л оношлодог байснаас нарийн оношилж чаддаггүй байсан. Одоо бол молекулын төвшинд оношлогоогоо сайн хийнэ. Өөрөөр хэлбэл, хүнийг элэгний вирустай байна гэдгийг оношилдог байснаас биш тухайн вирус нь А,С,В гэдгийг тодорхойлж чаддаггүй байсан гэсэн үг. Одоо бруцеллёз өвчнийг ийнхүү нарийн мэддэг болж байгаа учир өвчнөөс хэрхэн урьдчилан сэргийлэх, ямар арга хэмжээ авах зэргийг улам илүү тодорхой болгож чадна.
-Иргэд танай лаборатортой шууд харьцах уу. Эсвэл Улсын Мал эмнэлгийн ариун цэврийн төв лаборатороор дамжуулж харилцах уу?
-Улсын Мал эмнэлгийн төв лаборатор нь аймаг, орон нутгийн мал эмнэлэгүүдээс ирж байгаа дээжинд шинжилгээ хийдэг. Тиймээс иргэд орон нутгийнхаа мал эмнэлэгт хандах шаардлагатай. Тухайлбал, хээл хаяад байгаа малаа малын эмнэлэгтээ үзүүлэх хэрэгтэй. Харин малын эмч нь дээж аваад, журмынхаа дагуу хаяглаад явуулсан тохиодолд малын бруцеллёзын лавлагаа лабораторт инжлээд, буцаагаад орон нутгийн мал эмнэлэгийнгазар руугаа хариуг нь өгнө.
-Энэхүү лабораторт аймгуудын мал эмнэлгийн лабораториын ажилчдаас дадлагажуулах боломж байх уу?
-“Бруцеллёзын лавлагаа лаборатори” лаборатори байгуулагдснаар мал сүргийг оношлоход ашигладаг ийлдэс судлалын аргуудыг баталгаажуулах, оношлогооны ерөнхий чанарыг сайжруулах боломжтой болж байгаа гэдгийг хэлсэн. Түүнчлэн тус лаборатори аймгуудын мал эмнэлгийн лабораториудын оношлох ур чадварыг тогтмол үнэлж, мэргэжил арга зүйн туслалцаа үзүүлэх, боловсон хүчнийг сургаж дадлагажуулах нөхцөл бүрдэж байгаа. Өөрөөр хэлбэл цаашид малын бруцеллёзын оношлогоог олон улсын төвшинд хүргэхэд уг лабортори чухал үүрэг гүйцэтгэнэ.
Монголын мэдээ
URL:




